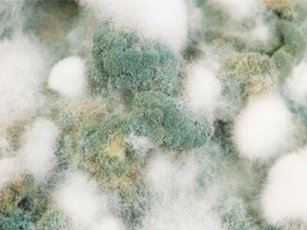

Tìm kiếm: hiện-tượng-nóng-lên-toàn-cầu
Đó là lời nhận định của Tổng thư ký Liên Hợp Quốc António Guterres.
Biến đổi khí hậu gây ra nhiều tác hại lớn đối với con người và thiên nhiên. Một trong số đó là sự suy giảm chất lượng nông sản, khiến thức ăn ngày càng ít và đắt đỏ. Sau đây là 10 sản phẩm nằm trong danh sách các loại thực phẩm có nguy cơ ít đi nhiều trong tương lai.
Sau khi khám nghiệm xác 6 con cá mập trắng trôi dạt vào các bãi biển ở Nam Phi, các nhà khoa học Anh đã nhận thấy chúng đều bị giết và xé toạc thân chính xác ở một vị trí để rồi gan, tim và tinh hoàn biến mất.
Một nghiên cứu từ Trung Tâm Không Gian Goddard trực thuộc NASA đã chỉ ra rằng, những lớp băng ở Nam Cực đang dày lên đến mức đủ để chống lại quá trình tan băng do hiện tượng nóng lên toàn cầu gây ra.
Cơ quan hàng không vũ trụ Mỹ NASA đã công bố một loạt các bức ảnh về Trái Đất chứng minh biến đổi khí hậu là có thật.
Huyền thoại về tộc người "kiểm soát lửa để tạo ra nước" ở vùng đất chết chóc nay thuộc New Mexico đã được hé lộ bởi các nhà khoa học Mỹ.
Sự tan chảy hoàn toàn của tảng băng Greenland có thể làm tăng mực nước biển lên 7 mét vào năm 3000. Và nếu điều đó xảy ra, đại dương sẽ nuốt chửng các thành phố ven biển trên toàn cầu.
Các nhà khoa học đã đưa ra lời cảnh báo rằng, trái đất sẽ chính thức bước vào thời kỳ nhiệt độ giảm mạnh - có thể coi là "tiểu băng hà".
Kể từ Ngày Trái Đất đầu tiên được tổ chức vào năm 1970, nhân loại đã làm sạch Trái Đất hơn rất nhiều nhưng vẫn còn đó những thách thức mới.
DNVN - Netflix vừa đưa ra gợi ý 9 bộ phim hay cho người Việt trong dịp Tết Canh Tý 2020. Lý do là nhu cầu đi du lịch dịp Tết Nguyên đán của người Việt ngày càng tăng. Gợi ý của Netflix nhằm đáp ứng nhu cầu giải trí của người dùng trên hành trình di chuyển trong đợt nghỉ Tết nguyên đán năm nay.
Chính trị và kinh tế luôn song hành, do vậy, tác động của biến đổi khí hậu đối với an ninh quốc gia là không thể phủ nhận.
Xác con vật được tìm thấy trong vùng băng giá vĩnh cửu ở miền Viễn Đông của nước Nga. Các nhà khoa học ước tính mẫu vật thời tiền sử có hơn 18.000 năm tuổi.
Sự lây lan nhanh chóng một dạng nấm candida mới trên toàn thế giới có thể là do nhiệt độ tăng liên tục trên Trái đất trong nửa thế kỷ qua. Điều này cho thấy các dịch bệnh khác của bệnh nấm có thể đe dọa loài người.
Thế giới đang kỳ vọng sự kiện COP 24 lần này có thể hồi sinh Thỏa thuận Paris sau khi Mỹ rút khỏi hiệp định này.
Ở bộ tộc này, những cô gái mới lớn sẽ được chỉ dạy kỹ càng về chuyện chăn gối, sau đó thoải mái lựa chọn chàng trai mình thích. Nếu muốn làm “chuyện ấy” với chàng trai nào, cô gái chỉ cần đẩy họ ngã khi đang cùng nhau nhảy múa.
End of content
Không có tin nào tiếp theo